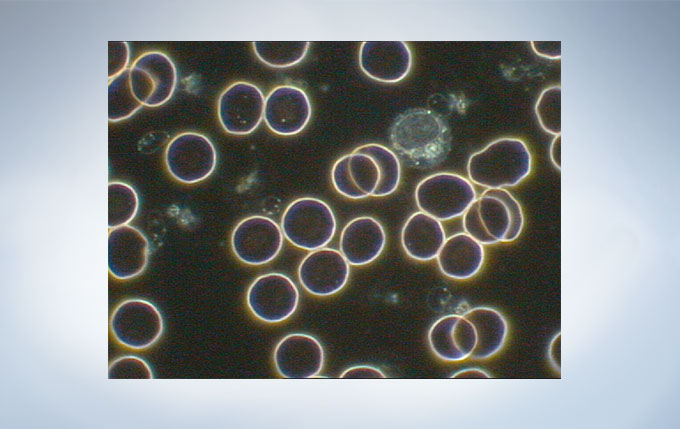
8fadc962e6104ed59e3aa9a6d2152cc7_20200213163317_90524.jpg

400-8760-400
在使用奥林巴斯CX43显微镜做常规镜检操作者会倍感舒适。因为这台将人手与控制旋钮进行很好匹配的显微镜镜架,最大程度地符合了人体工学的要求,提高了工作效率。此外,操作者在使用一只手调节焦距和载物台的时候,另一只手可以迅速地放置样品,从而使得操作动作最少化。同时,CX43显微镜带有用于数字成像的摄像端口。
照明均匀且色温恒定
LED 光源产生日光照明条件,使样品呈现自然色彩。它的色温在不同亮度下都维持恒定,即使用户改变亮度,也不必耗时调节。LED设计寿命6万小时,不仅降低维护成本,而且使用期间亮度稳定。

适于平坦影像的光学性能
显微镜采用平场消色差物镜,让大视野观察图像清晰且平整度更好。这使用户在常规显微观察时,样品既清晰又均匀平坦。

操控孔径光阑以增强反差
垂直移动聚光镜提高反差和缩小孔径光阑提高反差,两者效果相同。因此,通过有效地反差调节操作,可取得更好地图像。

保持反差水平
通过锁定孔径光阑,您能维持偏爱的反差水平。即使更换玻片时偶然触碰,孔径光阑仍能固定在选择位置。

固定柯勒照明获取显微观察
CX43采用新技术“柯勒照明(视场光阑固定)”,使用户无需调整聚光镜即能获取有效的照明。 该技术也避免了误操作,因而使CX43总能提供最佳的可视效果。而且作为标准,从2X到100X都适用该技术。

简便的荧光观察
荧光观察简单易用。将紧凑型荧光照明器插入显微镜机架即可进行荧光观察。它的LED 光源已预对中,只需将聚光镜设置到FL 位置即可阻挡透射照明。这减少了聚光镜顶透镜杂光所引起的荧光图像中的背景噪音。

单手放置样品
单手可快速滑入和滑出样品。操作中,样品夹略微打开并牢固固定样品。通用型样品夹适用多种玻片类型,如血细胞计数器。

平滑地倍率切换
低位物镜转盘使用户在聚焦中以微小手臂运动实现快速的放大倍率切换。这在长时间使用过程中大大提高了工作效率。

同时可用5 支物镜
为了增加灵活性,物镜转盘可同时支持5 支物镜。除了常规物镜,用户也可选择大视野的2X 物镜和相差物镜。这些物镜工作距离长,避免了样品的接触损坏风险。

符合人机工程学的聚焦旋钮
低位聚焦旋钮,使用户可将手和前臂放置桌面来进行观察,提高舒适性。使用聚焦限位旋钮避免了高倍物镜下损坏样品现象的发生。

人机工程学载物台和目镜位置
低位载物台设计提高了舒适性且减轻了疲劳感。从眼点位置可大范围观察载物台表面,使用户舒适放置和查看载物台上样品。载物台旋钮和调焦旋钮靠近,可在调焦同时轻松控制载物台移动。

样品夹匹配您的观察习惯
当用户需要观察大量样品时,载物台附件提高了工作效率。当使用样品垫时,用户可在薄垫上用单手指自由移动样品或使用载物台旋钮精细调节。双样品夹可夹持大尺寸样品或两片普通样品。

简易荧光观察
荧光观察可在标准配置基础上轻松建立,而且其眼点高度与其他观察方法相同。从显微镜机架后部插入荧光照明器即可开展荧光观察。

满足不同需求的应用
通用型聚光镜提供了多种观察方法以及将来升级的可行性。结合五孔物镜转盘,单一显微镜机架可涵盖多种应用。
简易偏光用中间附件/CX3-KPA
与起偏镜和检偏镜组合,提供尿酸盐晶体和淀粉的偏光观察。

眼点调节器/ U-EPA2
提升眼点高度 30 mm以增加舒适性。

箭头指示器/ U-APT
将LED箭头插入图像中; 非常适合数字成像和演示。

双人共览附件/U-DO3
双人以同样的方向、放大倍率和亮度,同时观察一个样品。指针可用来指示样品的特定部位,从而简化培训进程和增强讨论效果。

增强型配件

明场:宫颈细胞学

明场:结核病

明场:白细胞(调小光阑)
暗场:红细胞和白细胞

相差:HeLa 细胞

荧光:肾小球
观察方法 | 明场 | |
暗场 | ||
相衬 | ||
荧光(蓝/绿激发)(仅蓝激发) | ||
简易偏光 | ||
照明器 | 透射式柯勒照明器 | LED灯 |
荧光照明器 | LED灯 | |
聚焦 | 聚焦机制 | 载物台聚焦 |
手柄行程 | 15 mm | |
特性 | 粗调限位器粗调焦旋钮的张力可调节 | |
物镜转盘 | 手动 | 标准(5孔) |
载物台 | 手动 | 带右手控制旋钮的机械式载物台内置X: 76 mm, Y: 52 mm |
聚光镜 | 手动 | 阿贝聚光镜NA 1.25 (2X–100X) |
观察筒 | 标准 (FN18) | 倾斜双目 |
镜筒 | 标准 (FN20) | 双目镜筒 |
三目镜筒 | ||
观察 | 镜筒倾斜角度 | 双目、三目30°倾斜双目30–60° |
三目镜筒光路(相机:肉眼观察) | 50% : 50 % | |
瞳间距调节 | 48–75 mm | |
尺寸 | 211 (W) x 376 (D) x 393 (H) mm (标准配置) | |
重量 | 大约 7.3 kg | |